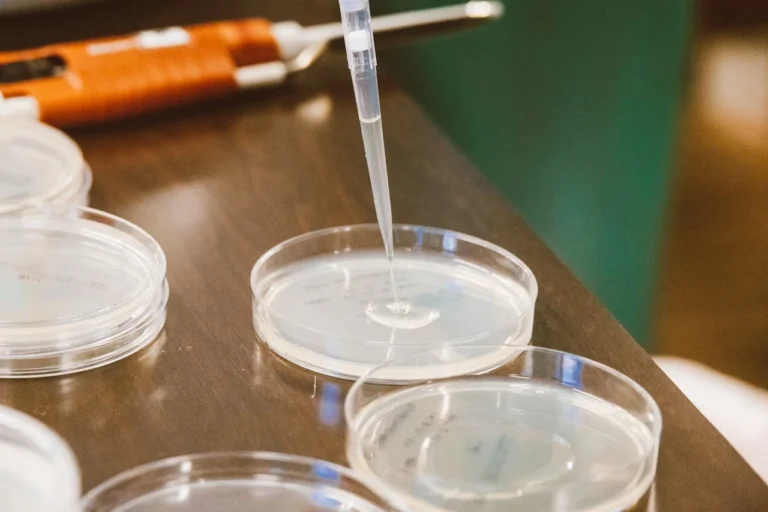
grasa en heces

Entrada de la categoría:
Seguros Torrelodones

Día Internacional de la Discapacidad: Inclusión, derechos y protección
Por Seguros Torrelodones• 3 diciembre, 2025Celebramos el Día Internacional de las Personas con Discapacidad. Descubre la importancia de la inclusión y cómo los seguros pueden ofrecerte la tranquilidad.
Día Internacional de la Tolerancia: Respeto activo
Por Seguros Torrelodones• 16 noviembre, 2025El 16 de noviembre, el calendario global te pide que hagas un examen de conciencia profundo. Es el Día Internacional de la Tolerancia, una conmemoración que te exige más que...
Día Internacional contra el Cambio Climático: un llamado a la acción global urgente
Por Seguros Torrelodones• 6 noviembre, 2025Día Internacional Contra el Cambio Climático: Te explicamos el origen del 24 de octubre, la ciencia detrás de los 1.5ºC y cómo puedes actuar hoy.
Día Mundial de la Salud Mental: ¿Qué significa realmente para ti y cómo empezar a cuidarte?
Por Seguros Torrelodones• 29 octubre, 2025Día Mundial de la Salud Mental (10 oct). Descubre las 5 señales de alerta de tu mente y la hoja de ruta práctica para tu auto-cuidado diario. ¡Priorízate!
Astroturismo en España: conoce los mejores lugares
Por Seguros Torrelodones• 24 octubre, 2025¿Sueñas con ver las estrellas? Explora los mejores lugares de España para el astroturismo. Una guía con destinos, consejos y equipo para tu viaje.
Día Mundial del Turismo: Celebrando una pasión que mueve al mundo
Por Seguros Torrelodones• 22 octubre, 2025En el Día Mundial del Turismo, celebra el poder de viajar. Descubre cómo explorar el mundo te transforma y qué impacto positivo puedes generar.
¿Me pueden multar en un parking? La respuesta, con matices y normativa española
Por Seguros Torrelodones• 8 octubre, 2025Entender la titularidad del parking es clave para evitar multas. Te explicamos los matices de la ley y cómo conducir de forma segura en cualquier aparcamiento.
Vacaciones en la montaña en España: tu guía completa
Por Seguros Torrelodones• 30 septiembre, 2025Prepara tu aventura en las montañas de España. Descubre los mejores destinos, qué empacar y cómo planificar para disfrutar al máximo y con seguridad.
El síndrome de Stendhal: ¿Qué es la belleza que abruma?
Por Seguros Torrelodones• 26 septiembre, 2025Descubre el síndrome de Stendhal, un fenómeno donde la belleza causa síntomas físicos y psicológicos. Aprende a gestionarlo con la ayuda profesional.
Grasa en heces: qué significa y cuándo preocuparse
Por Seguros Torrelodones• 24 septiembre, 2025Si tu médico te pidió una prueba de grasa en heces, descubre qué revelan los resultados y cómo este análisis es clave para tu salud digestiva.